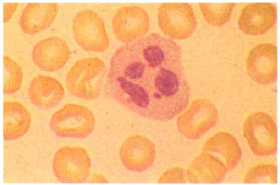
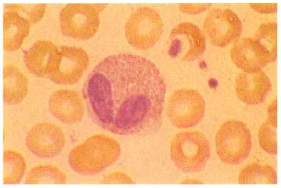
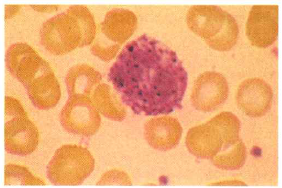
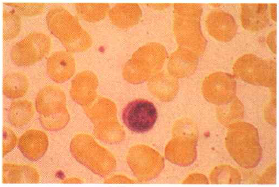

What are the asterisk and arrows in this image?

Gastrointestinal mucosa (asterisk) and cartilage (arrows).
What type of cell is this? And what is the characteristic structure?
Polymorphonuclear leukocyte and Multisegmented nucleus.
What kind of cell is this? And what is the characteristic structure?
Eosinophil and Bilobed nucleus.
What does the cell contain?
Intracytoplasmic basophilic granules.
What is the characteristic structure of the cell?

Indented nucleus.
What type of cell is this? And what is the characteristic structure?
Lymphocyte and small, hyperchromatic nucleus.
What type of cells are in this image?

Epithelioid histiocytes.
What are the arrows seen in this image? And what is their classification?

Granulomas with necrotic centers and Caseating granulomas.
What kind of cell is this? And what is the characteristic structure?

Langhans giant cells and Horseshoe arrangement of the nuclei.
What type of cell is this? And what surrounds the nuclei?

Touton giant cell and it is surrounded by a lipid-filled clear zone.
What kind of cell is this? And what is the characteristic structure?

Foreign body giant cell and haphazardly arranged nuclei.
What is the growth pattern of hematopoietic neoplasm?

Loosely arranged.
What is the growth pattern of epithelial neoplasm?

Cords, tubules.


